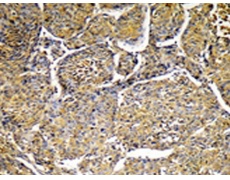
一抗

|
Background: |
Involved in bile acid synthesis and is responsible for the conversion of 7 alpha-hydroxy-4-cholesten-3-one into 7 alpha, 12 alpha-dihydroxy-4-cholesten-3-one. Responsible for the balance between formation of cholic acid and chenodeoxycholic acid. Has a rather broad substrate specificity including a number of 7-alpha-hydroxylated C27 steroids. |
|
Applications: |
WB, IHC |
|
Name of antibody: |
CYP8B1 |
|
Immunogen: |
Synthesized peptide derived from internal of human Cytochrome P450 8B1. |
|
Full name: |
cytochrome P450, family 8, subfamily B, polypeptide 1 |
|
Synonyms: |
CP8B; CYP12 |
|
SwissProt: |
Q9UNU6 |
|
IHC positive control: |
Human liver carcinoma tissue |
|
IHC Recommend dilution: |
50-100 |
|
WB Predicted band size: |
58 kDa |
|
WB Positive control: |
293 cells lysate |
|
WB Recommended dilution: |
500-3000 |


 購物車
購物車 幫助
幫助
 021-54845833/15800441009
021-54845833/15800441009